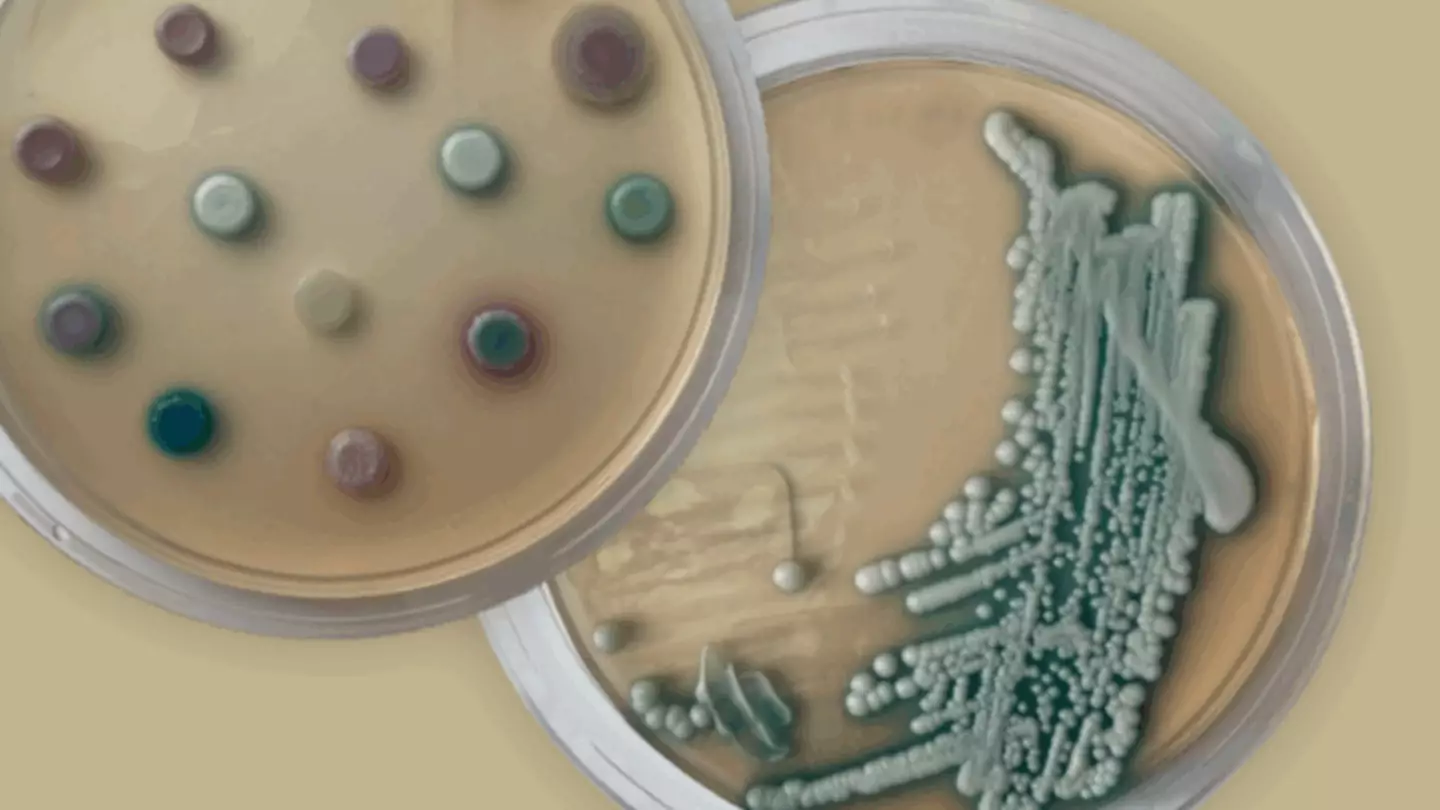

A life-threatening fungus has been identified in the UK and health experts have revealed why its 'remarkable resilience' makes it 'particularly concerning'.
Candidozyma auris (C. auris) - previously known as Candida auris - is a fungal pathogen that's 'gaining attention from health authorities worldwide'.
The UK Health Security Agency (UKHSA) said in a recent blog post that C. auris can 'survive on surfaces for weeks' and that certain people are at risk of infection.
What is C. auris and how does it spread?
C. auris is a fungus which can pose a serious threat, particularly in healthcare settings. It can live on the skin without causing symptoms and may lead to severe infections if it enters the body.
The fungal pathogen spreads through contact with contaminated surfaces, medical equipment, or directly from person to person.
Advert
Often it has been found on hospital items like beds, sinks, and stethoscopes. But because it survives on surfaces for long periods and resists most antifungal treatments, the UKHSA has issued a warning.

Illnesses caused by C. auris
Although some patients 'may carry the fungus without symptoms' it seems that 'others develop serious infections such as infections in the blood, brain and spinal cord, bones, abdomen, wounds, ears, respiratory tract, and urinary system'.
"People who are carrying the fungus are still at risk of developing an infection or passing it on to others," the UKHSA added.
Who is at risk of infection?
The UKHSA noted that 'it rarely causes infections in healthy individuals'. However, it can be threatening to those 'who are critically unwell' in hospital 'and/or who have weakened immune systems'.
Advert
"While not as widespread in England as in some other countries, C. auris has caused outbreaks in several healthcare settings in England (fewer than 700 cases have been detected to date)," they said.
"We monitor C. auris cases and are working in partnership with the NHS, independent sector healthcare providers and other stakeholders to limit its spread and support the identification of appropriate treatment options."

WHO classes C. auris as a fungi which poses a 'serious threat to humanity'
In a 2022 report, the World Health Organisation (WHO) listed the C. auris among 19 fungi that pose a 'serious threat to humanity'.
Advert
Dr Hanan Balkhy, WHO Assistant Director-General, Antimicrobial Resistance (AMR), said: "Emerging from the shadows of the bacterial antimicrobial resistance pandemic, fungal infections are growing, and are ever more resistant to treatments, becoming a public health concern worldwide."
Dr Norman van Rhijn from the University of Manchester, told Sky News that infections which spread from the lungs to other organs kill 1.8 million people globally each year.
“Most fungi live in the environment,” he said. “Because that environment is rapidly changing, we will definitely see different kinds of diseases and infections popping up over the next 50 years or so.”
How to prevent C. auris from spreading
The UKHSA advises:
- Washing hands with alcohol-based hand rubs or soap and water
- Active surveillance to identify colonised or infected patients early
- Appropriate management of infected patients within healthcare settings
- Thorough cleaning of the hospital environment using appropriate disinfectants
- Using single-use equipment where possible, and making sure that reusable items undergo effective decontamination
- Careful use of antimicrobials to help prevent strains of C. auris becoming more resistant to treatments